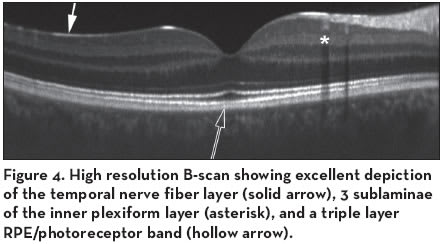
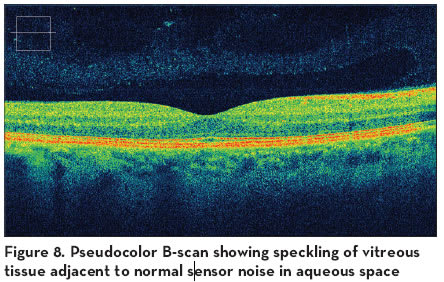

Next-generation OCT: What to Look for in a Fourier Domain OCT Instrument
ALEXANDER C. WALSH, MD
Fourier domain optimal coherence tomography (FD-OCT), also known as spectral or frequency domain OCT, is quickly overtaking conventional time domain OCT (TD-OCT) as the clinical standard for the next decade.With superior speed, resolution, and sensitivity, FD-OCT may be the ideal solution for any new OCT purchase. However, there are important differences between time and Fourier domain OCT technologies. As a relatively new tool, FD-OCT’s hardware and software are evolving rapidly. Therefore, potential buyers should do their homework, survey competitive features between instruments, and enter cautiously into this large capital investment. This introductory guide to FD-OCT devices is intended for physicians interested in selecting an FD-OCT instrument for clinical use. Although a detailed explanation of FD-OCT is beyond the scope of this article, various features and desirable instrument capabilities will be discussed. Instrument characteristics will be separated into 3 categories: hardware specifications, image quality, and software features. The reader is reminded that this summary is by no means a final answer – it is merely a starting point for the questions that need to be considered when choosing the right instrument for your practice.
Alexander C. Walsh, MD, is assistant professor of ophthalmology at Doheny Eye Institute, Retina Division, and the University of Southern California’s Keck School of Medicine in Los Angeles. Dr. Walsh shares royalties from software licensed to Topcon Corporation by the Doheny Eye Institute.
HARDWARE SPECIFICATIONS
When it comes to FD-OCT, the light source, the speed of the image sensor, and the instrument’s non-OCT imaging capabilities all are important specifications to consider (Table). The axial resolution, or size of the smallest structure that can be resolved along the axis of the eye, is determined by the light source in the OCT machine. Broader bandwidth sources produce finer, or higher, axial resolutions. Recent progress in the field of broadband superluminescent diodes (SLDs) has made high resolution (4 to 7 μm) OCT more affordable. As advanced SLD and laser technologies become cheaper, commercial ultrahigh resolution (2 to 3 μm) machines should also become available. Image acquisition speed may be just as important as axial resolution when choosing an FD-OCT machine.With TD-OCT, individual point scans, known as A-scans, must be aligned along their vertical axis to produce a B-scan. This can result in distortion of the normal retinal curvature (Figure 1a), as well as attenuation of disease features such as drusen and retinal pigment epithelial (RPE) detachments. In

contrast, FD-OCT has the potential to be up to 100 times faster than TD-OCT and may better preserve the anatomical relationships of the tissue being imaged (Figure 1b). Unlike TD-OCT instruments, which allows only sparse data to be gathered, high-speed OCT enables complete coverage of the macula. These dense FD-OCT scans, known as 3D-OCT scans, enable stunning 3-dimensional retinal reconstructions (Figure 2) and are a “must-have” function in any FD-OCT device. The fast scanning speeds that enable 3D-OCT should also translate into more efficient patient flow, better patient comfort, fewer chances for disruptive eye movements, and more opportunities for the machine to con-


trol noise with oversampling. On the flip side, speed may affect image quality – especially in patients with anterior segment abnormalities. Therefore, when evaluating a machine’s performance, always look beyond the demonstration images to the rapidly acquired 3D-OCT images, which may be more similar to data collected in a routine clinical setting. Bundling of non-OCT imaging modalities, such as the line-scanning laser ophthalmoscope (LSLO) (Figure 3a), fluorescein angiography (FA), indocynanine green (ICG), autofluorescence, or microperimetry (Figure 3b), into an FD-OCT device has its pros and cons. For the clinic that wants to add 1 or more of these capabilities to its armamentarium, instruments that offer these additional imaging

functions may seem attractive. These devices may also offer point-to-point comparisons between OCT and non-OCT images that assist in diagnostic or management decisions. However, concentrating too many critical functions into a single machine can also be problematic if the device breaks down or if many patients requiring only OCT scans are held up by patients receiving long angiography and/or microperimetry studies. Finally, do not forget to consider the overall ergonomics of the device hardware as well as the service and support reputation of the manufacturer. Instruments that are difficult to use or repair may be more of a headache than they are worth.
IMAGE QUALITY
When adjusted properly, FD-OCT machines should have higher sensitivity than TD-OCT instruments. Coupled with higher axial resolution, this often results in the appearance of previously unapparent interfaces and structures. For example, the temporal macular nerve fiber layer, sublamina within retinal layers (Figure 4), “triple” RPE/photoreceptor interface, and possibly even Bruchs membrane may become visible. The higher sensitivity of FD-OCT comes at a price, however. FD-OCT machines have a “sweet spot” of maxi-

mum sensitivity (and therefore image quality) that resides either on the vitreous or the choroidal side of the retina. Furthermore, the quality of an FD-OCT B-scan changes as the tissue moves vertically on the screen (Figure 5). Therefore, prior to capture, the operator may need to select which tissue to image with higher sensitivity (inner retina or choroid) and then keep the patient’s eye in a position that maximizes this signal. Some FD-OCT machines may be more susceptible than TD-OCT devices to media opacities such as cataracts and corneal disease. In these cases, greater amounts of noise may obscure features like subretinal fluid and make it difficult to distinguish subtle findings from normal tissue. Therefore, it is a good rule of thumb to look for devices that

consistently produce a brighter signal in the outer retinal layers when compared to the vitreous (Figure 6). Don’t expect the vitreous to look black, however. Vitreous tissue interfaces should be visible with OCT and, in the case of vitreomacular traction syndrome, are critical components of the diagnosis (Figure 7).

Since grayscale images may hide the “speckles” that signify vitreous tissue (Figure 8) and mask noise problems, pseudocolor should be used to assess the quality of the vitreous signal as well as expose potential noise problems that can be hidden with grayscale images.
SOFTWARE FEATURES
The large datasets acquired by high-resolution FD-OCT instruments enable several new capabilities. Dense 3D-OCT scans produce integral maps that can be precisely aligned with non-OCT imaging modalities such as color fundus imaging (Figure 9).Well-designed FD-OCT instruments should include point-to-point registration capabilities that allow users to click on points
of interest either in the OCT or non-OCT image and see the corresponding point in the other modality (Figure 10). The invariant landmarks that enable precise OCT dataset alignment should also improve the accuracy of intervisit comparisons for a given patient.With proper software, the same point in the fundus can be compared between visits regardless of the patient’s ability to fixate, thus improving the reproducibility of longitudinal clinical measurements. As with FD-OCT’s higher sensitivity, all of these advanced capabilities come at a price. In order for an FD-OCT device to perform effective intervisit alignment or produce good 3D reconstructions of the retina, it must account for eye movements that occur during image acquisition. These movements happen on a time scale of tens to hundreds of milliseconds and can be quite large and frequent in patients with severe macular diseases and poor fixation. Since current 3D-OCT devices require substantially more than 100 ms to acquire dense macular scans, this problem will likely affect all FD-OCT instruments for the foreseeable future. And without accurate saccade correction,

precise intervisit alignment and point-to-point registration are not possible (Figure 11). Fortunately, effective eyetracking software can correct this problem.When evaluating FD-OCT machines, therefore, make sure to look at 3D reconstructions and intervisit comparisons from patients with poor fixation since these should readily demonstrate registration problems. In the era of TD-OCT, 6 radial B-scans could easily be printed, reviewed, and discussed with a patient. Now that 3D-FD-OCT instruments present clinicians with hundreds of B-scans at once, it will no longer be possible to print and review each of these B-scans individually.Ophthalmologists, therefore, will need to become comfortable and facile using FD-OCT software to review large 3D-OCT datasets in the presence of their patients. This will require easy-to-use, ergonomic software that can be operated by the entire clinic staff, not just the photographers. And although large 3D-OCT files can be transported from the instrument to the clinic on hard media such as CDs or flash memory keys, FD-OCT machines that integrate robust network support software may transfer large files more efficiently and rapidly across local networks directly to patient-care areas. Beyond large FD-OCT files, many OCT users have accumulated large banks of TD-OCT data that they will want to access in the future. For purposes of simplicity and efficiency, well-designed FD-OCT devices should therefore include the ability to import TD-OCT data to the new instrument’s database so that a single device can be used for OCT data storage and comparisons. Finally, software limitations in existing TD-OCT instruments have resulted in incorrect boundary identification and


frequent segmentation errors in some disease states. In an era of anti-vascular endothelial growth factor (VEGF) therapy guided by subretinal findings such as fluid and pigment epithelial detachments, it will be increasingly important for OCT software to correctly identify tissue boundaries and extract clinically relevant measurements from OCT images. In addition, high-resolution 3D-OCT devices can depict optic nerve topography and the retinal nerve fiber layer with unprecedented accuracy. Therefore, clinicians interested in using FD-OCT for glaucoma monitoring or screening should select an instrument that includes support for large multiethnic normative retinal thickness databases.
SUMMARY
When comparing hardware capabilities, look for highresolution 3D-OCT devices with rapid scanning speeds and good accessory imaging manufactured by a company with a reputation for service and support. An instrument’s image quality can be assessed by inspecting the outer retinal signal in 3D-OCT B-scans that have been acquired in patients with cataracts or corneal disease.To evaluate software features, look for a machine with an easy-to-use, ergonomic software interface, integrated network support, large multiethnic normative databases, and legacy support for TD-OCT datasets. Finally, make sure the device corrects for eye movements during OCT acquisition to improve the accuracy of intervisit and intermodality image alignment.
CONCLUSION
The FD-OCT revolution has just begun. This diagnostic tool is likely to be around for much of the next decade. Several associated technologies, such as Doppler, swept source, and full-field OCT, are on the horizon. In addition, 3D-OCT has the potential to replace current evaluations for glaucoma and provide an effective method of screening for epidemic causes of blindness such as diabetic retinopathy and age-related macular degeneration. Therefore, potential buyers should keep these issues in mind when comparing features among instruments and not rush into this important investment in a next-generation diagnostic imaging device.








